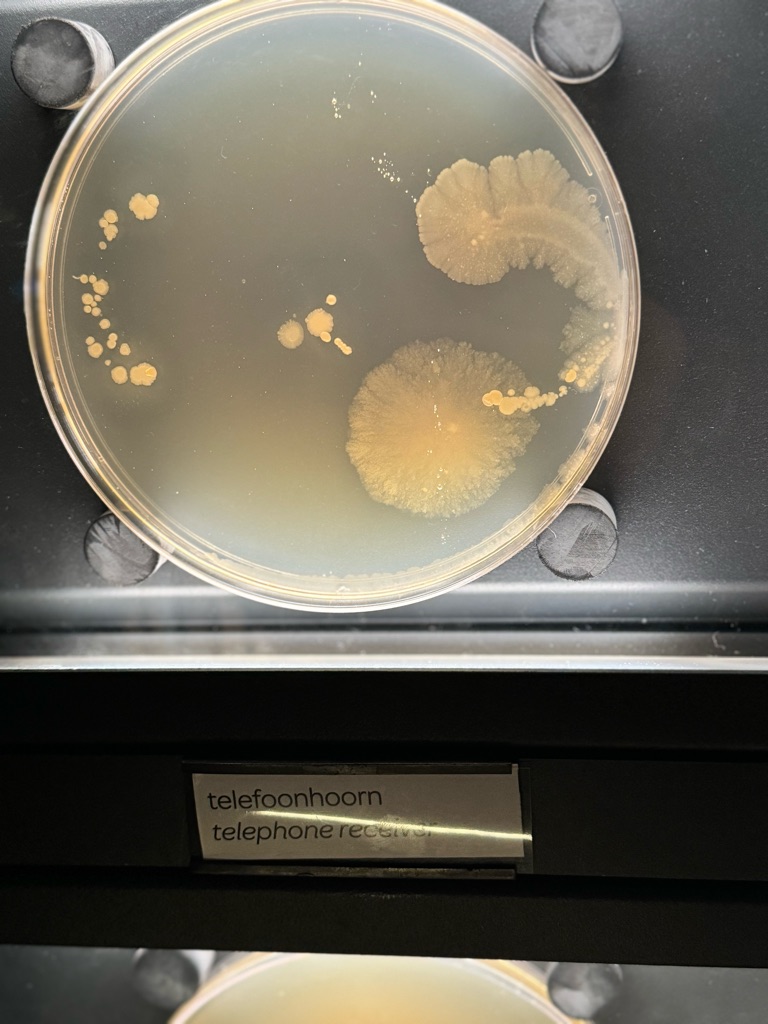
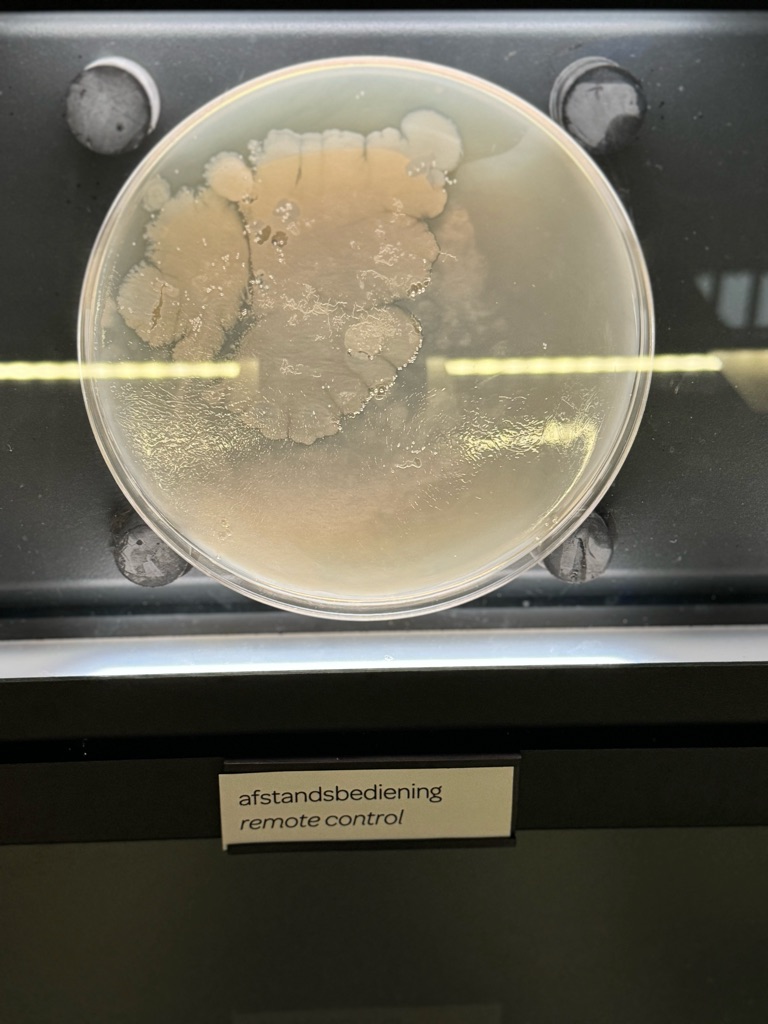
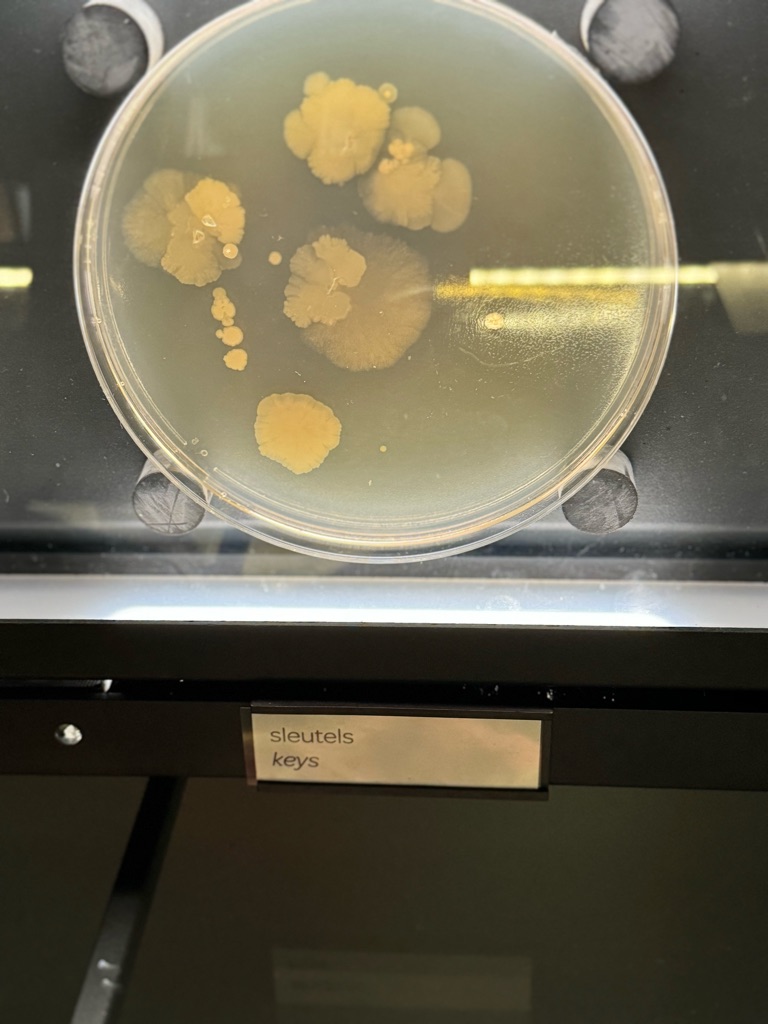
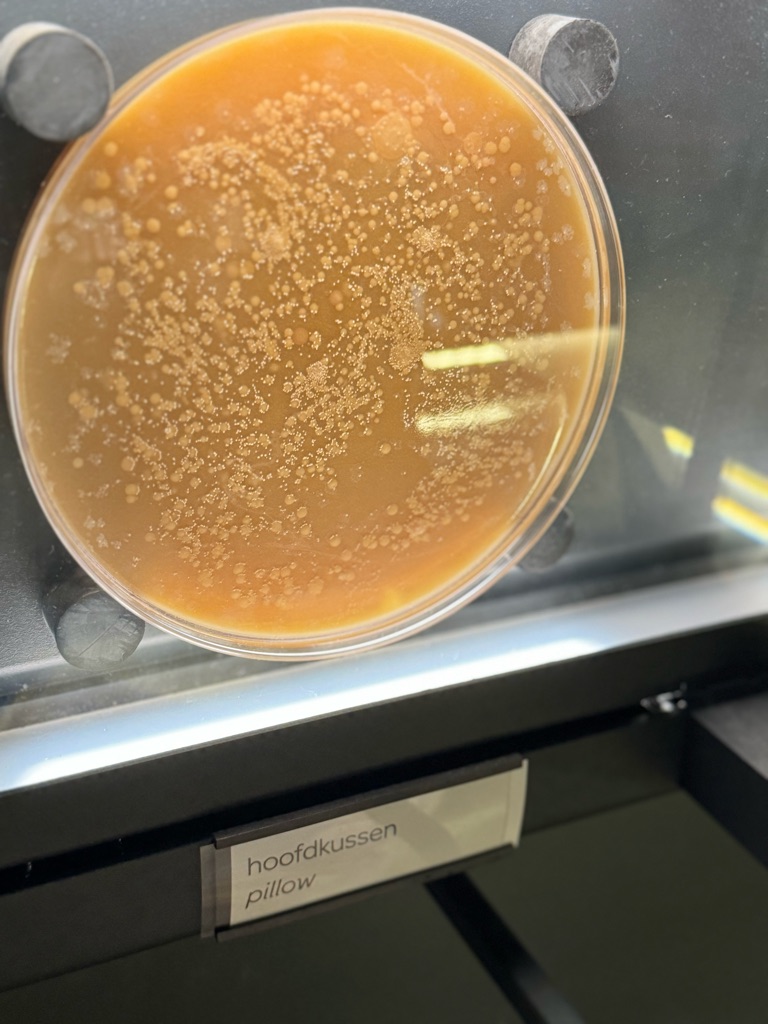

We made it to Lourdes what seemed like LATE last night. It really wasn’t late but felt like it. We had been awake for nearly 26 hours so everything seems late to us.
Here is a view from our window
There are a lot of people moving about already. I think everyone is heading over for mass or something. I don’t even know what building that is but that’s the direction everyone is going.
We were trying to make our way from Toulouse to Lourdes but desperately needed to stop for coffee. Most places in Europe close early for family time and I understand but sometimes you need a quick pick me up.
Looks wimpy but it’s a really good sandwich.
Pop and Auntie Zeny had smoked salmon sandwich. Pop liked it so much that he got another. Then again, the meals in KLM were so gross.
Quick stop for something to eat at the gas station. This place “Maison something” - (Check the window for complete name) is supposed to be famous for their macarons. Alas, we did not try it
Some pix of our drive from Toulouse to Lourdes into the Pyrenees 🥰
I better wake the Pilgrims now if they want to go to mass this morning.
I must be tired if I posted these pix more than once but now you know the background story
…and God said, “let there be coffee!” \240(Cue the choir of angels)
At least the lady who runs the breakfast place spoke to me in Spanish and I was so utterly grateful!! How did she know I spoke Spanish? Is it my hair? Haha
Lourdes, France (our hotel in background- Hôtel Saint Louis de France)
Can’t believe they FINALLY woke up! Haha
They battled the elements but did NOT drink the water 😵💫🥴😳
My hair is NOT greasy! It’s sopping wet from being in the rain
Walkway going down to the miraculous grotto.
The Folks were freezing because it started raining so we picked them up and had them defrost in the car. They were unable to make it to the grotto. They rested a little and we picked them to bring them BACK to get their water. In the meantime, we had a little time to kill so we discovered a little museum. It’s LITERALLY little. Even in their name!
Illegal photos of the inside of the sanctuary during mass
The Way of the Cross
(Le Chemin de Croix)
See? Le Petit Lourdes! Haha
Enjoy the pictures below!!
The artist who creates Le Petit Lourdes
The artist above was a miner (as in actually worked in the mines) and in his spare time he created this tiny rendition of Lourdes. He was originally from Lorraine.
All the photos are the inside of Notre Dame
We left the folks to rest and went to discover the rest of town
The basilica above took the artist 15 years to make and ONE solid piece of plaster.
The pictures above are all outside and depicts what Lourdes looked like when Bernadette was there. It took the guy 10 years to make.
Looks like we found this convent called St Claire’s. Haha
FINALLY, the folks are ready to get to the grotto (which they missed earlier due to the weather…) it would have been easier to walk across the bridge but it was pouring rain with wind! It was supposed to be leftover from Hurricane Milton. So we had to take the long way around and take the car. \240
Then BOOM AND BOOM!! We hit some weirdo pothole and this is what happened!! 😳
Whilst waiting for the folks, we walked a little up the street and found this convent -
And that’s the end of our rental car and we have a flight leaving from Toulouse (2 hours away from Lourdes) and no way to get there tomorrow. Will report more in a few moments. Just digest those 2 pictures above. \240
So, we had an hour + to wait for tow truck and in these torrential rain pour but. Pop still needed to get to the grotto. So we called a cab.
Pop had already filled his bottle of water (1L) and filling his water bottle for tonight and tomorrow before he flies to Paris.
The Virgin Mary and where the apparition occurred
Papa still hadn’t showed up from waiting for the tow truck, and we were waiting (worriedly) for him so we did some browsing and had to look for somewhere to eat. We are roughly 5,000 miles away from home and look what Pop and Auntie found…
Looks like we made it to the grotto at last!
I wonder if there is some Filipino food saint that protects and watches from above!! We are in the middle of the Pyrenees! How do they find these places???!
That being said, the food was awesome. I would totally recommend it others.
Because it was so cold and windy, he did not get to dunk in the baths, so I made him wash his face. Then Auntie Zeny, was just standing there and I told her to wash her face too! So she did and she said, “I have to rub it into. My ears so I can hear again!” Haha
We found this place that is similar (and much smaller than) Granville Island
The fine details of the basilica.
We were ordering our food when these 2 guys started to break out their Tagalog!! Crazy! They don’t Filipino at all.
To wrap up the day, we would definitely come back as long as someone leaves his Protestant heretic saint behind and allow the catholics to do their miraculous business and keep the bad omens away. He better start praying \240to one of our saints soon (just to keep us safe from these mischievous imps - AKA heretics!)
Oops! I forgot to include another place we went!